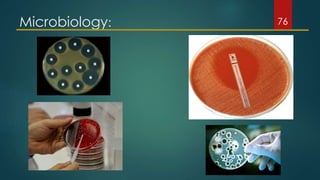
Microbiology: 76

This document provides an overview of laboratory investigations. It begins by outlining the need for lab investigations to supplement clinical findings. It then defines lab investigations and discusses their generic applications and classifications based on location, specificity/sensitivity, and frequency of use in dentistry. The document goes on to cover crucial questions to consider prior to ordering lab tests and provides examples of commonly used hematological, biochemical, microbiological, immunological, and histopathological investigations. It concludes by discussing common clinical scenarios where lab tests are useful.